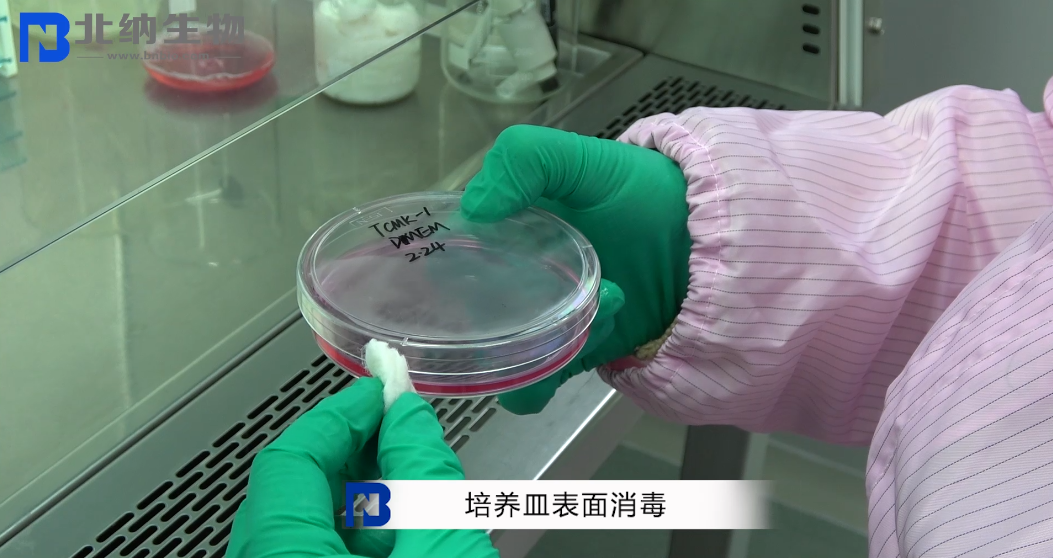
新闻图片4
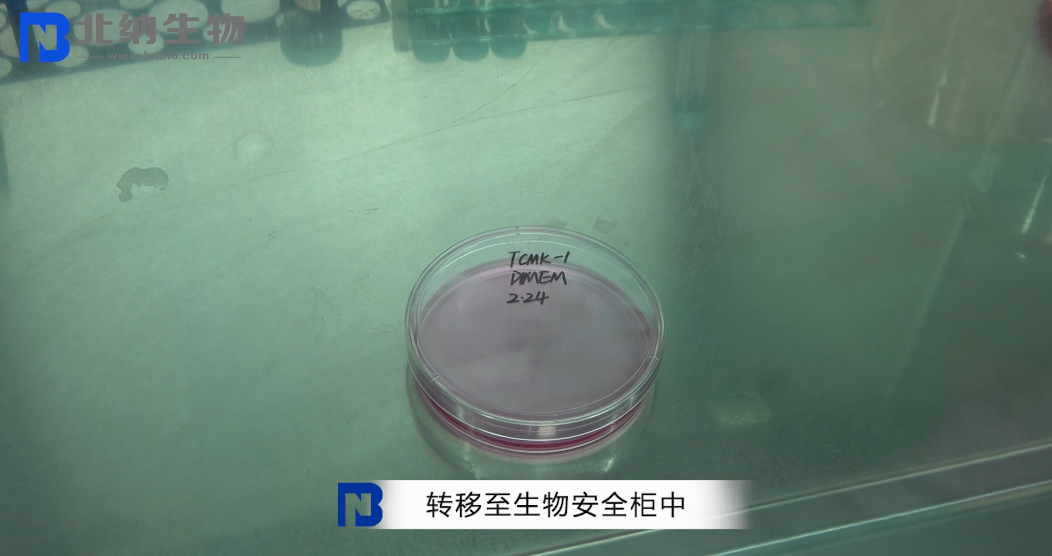
新闻图片5
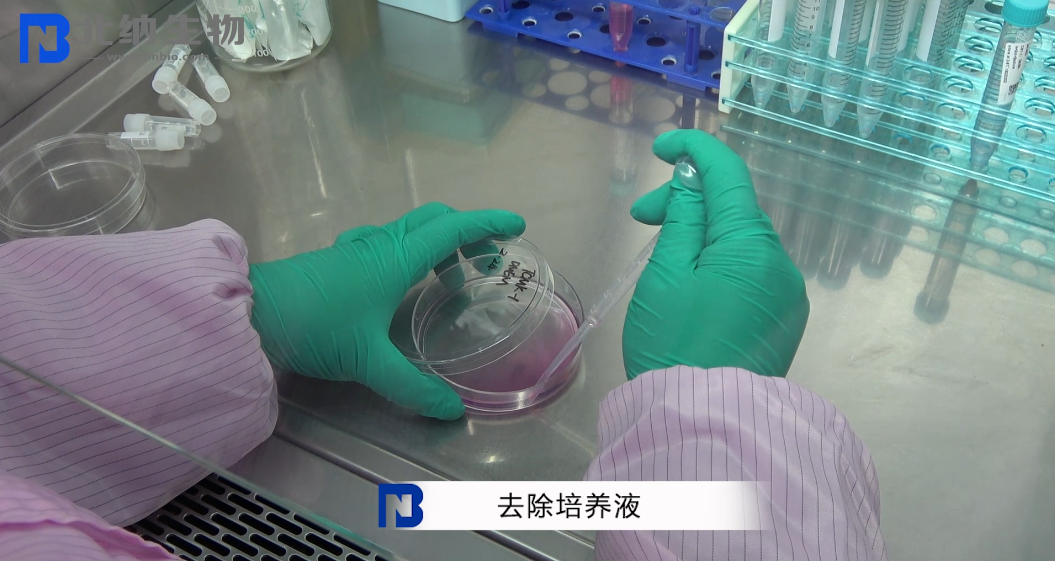
新闻图片6
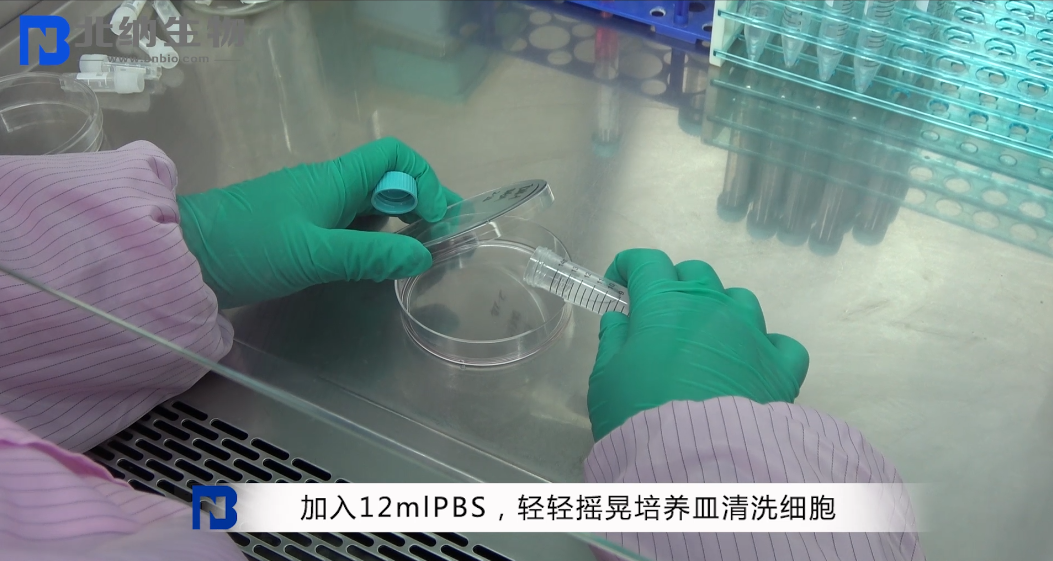
新闻图片7
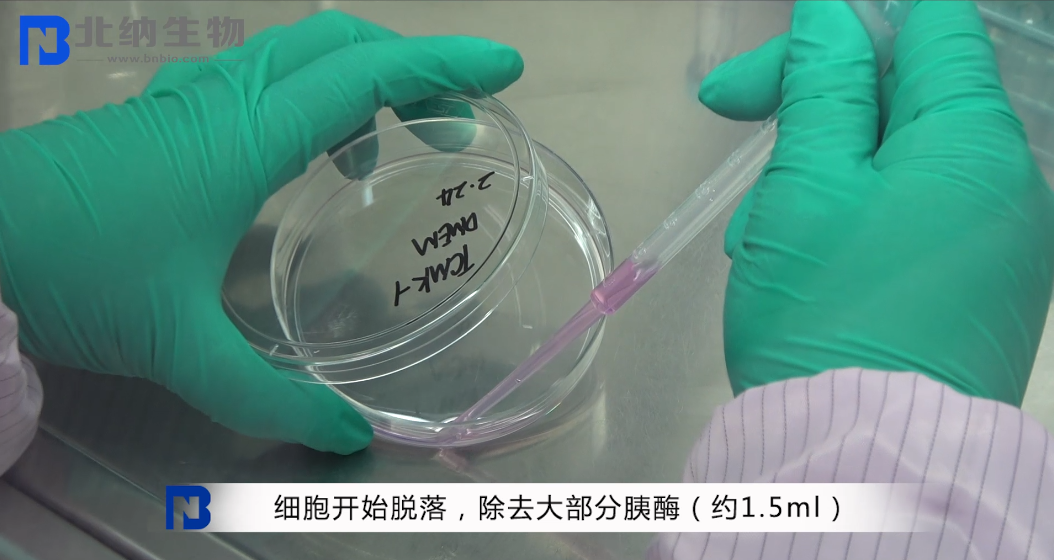
新闻图片11
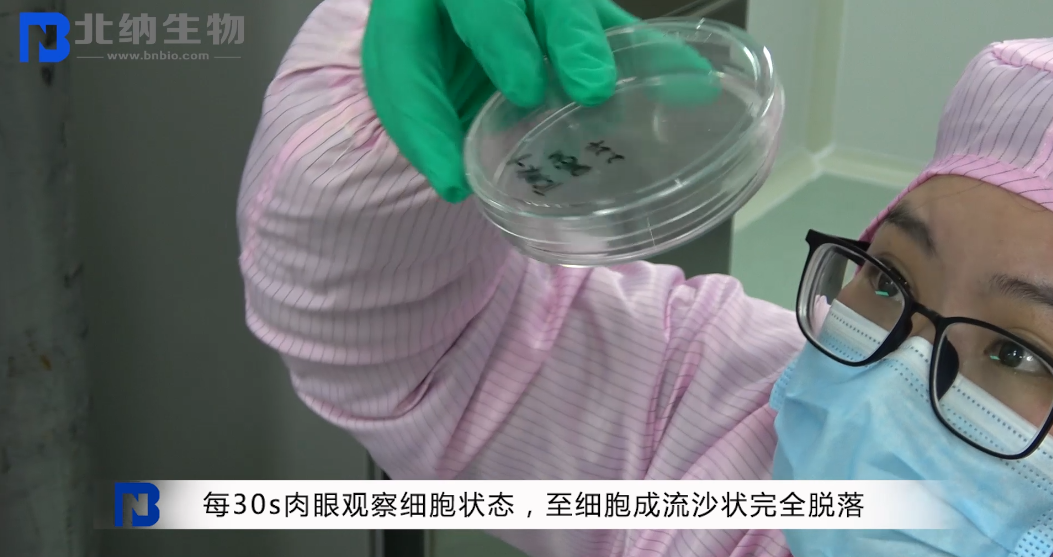
新闻图片14
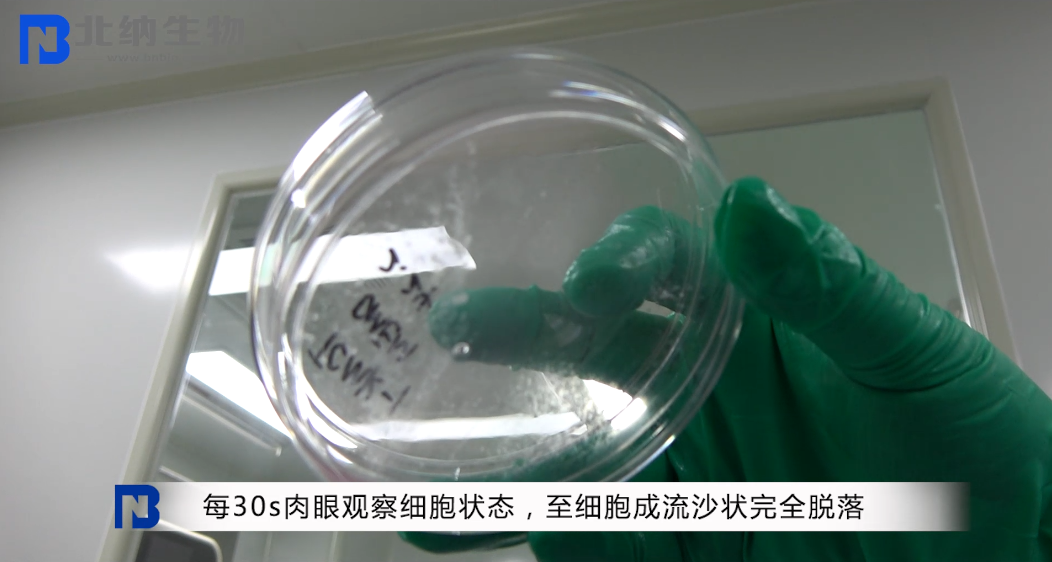
新闻图片15
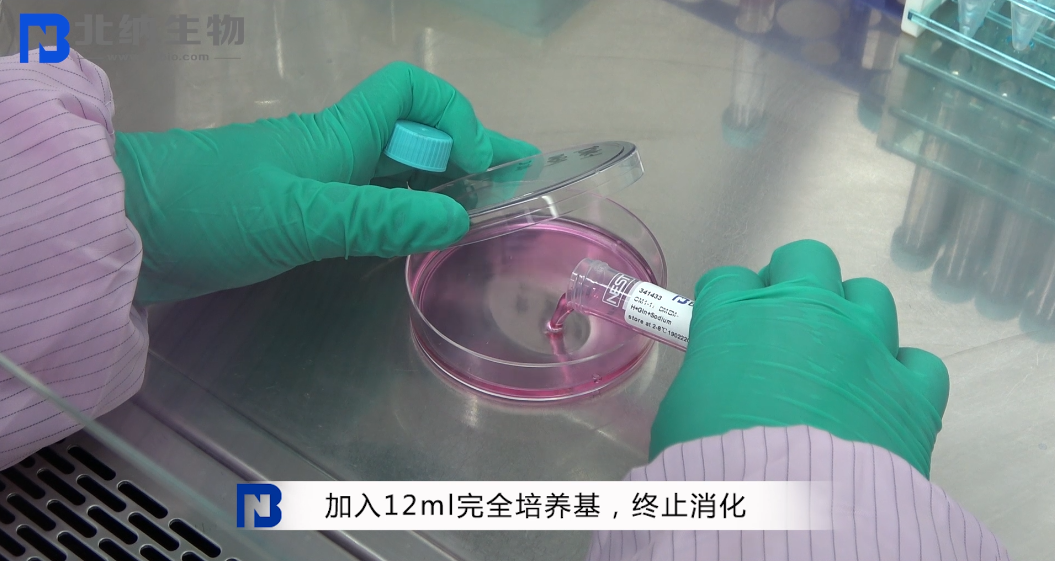
新闻图片16
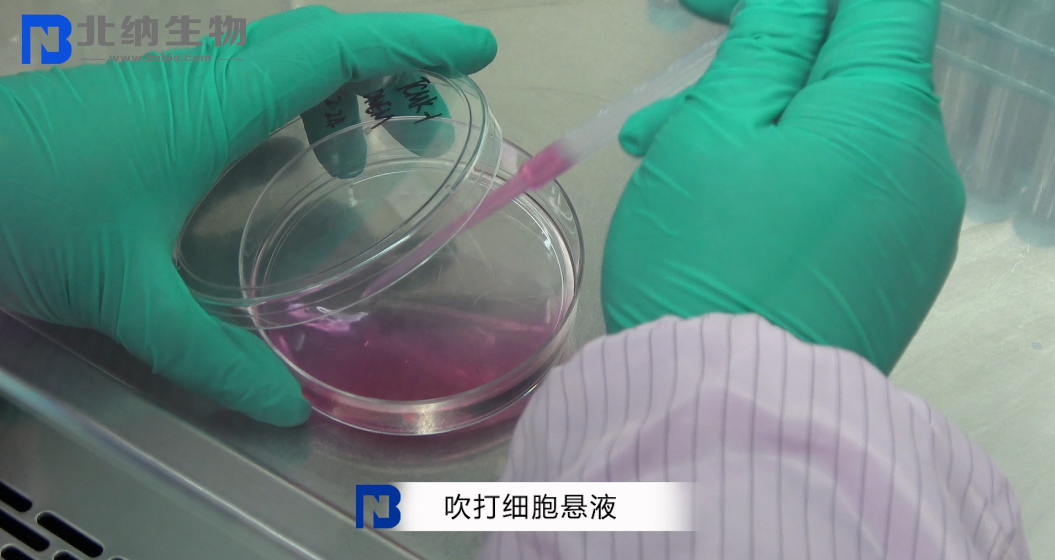
新闻图片17
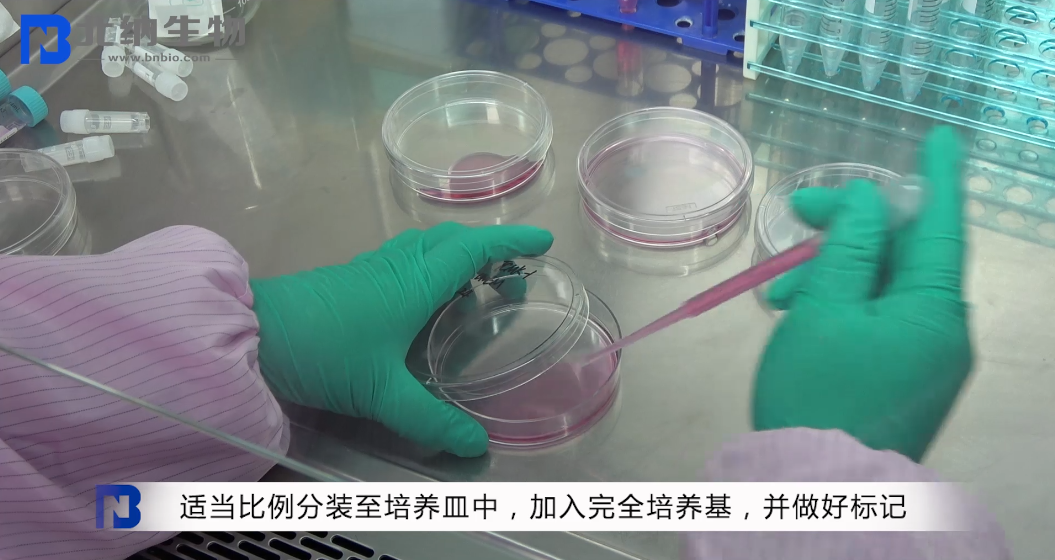
新闻图片18

北京北纳创联生物技术研究院
14 年
手机商铺
商家活跃:
产品热度:
- NaN
- 0.20000000000000018
- 0.20000000000000018
- 2.2
- 2.2
水系沉积物成分分析标准物质——北京标准物质网www.biaowu.com
询价
推荐产品
公司新闻/正文
贴壁细胞如何传代?
2005 人阅读发布时间:2020-06-02 09:59
传代是细胞培养最基本的操作,也是最容易出问题的环节。下面,北纳生物技术老师为大家演示了贴壁细胞的传代操作流程。欢迎查看!
1. 贴壁细胞密度达到 80%,即可进行传代,拍照,记录细胞状态。



2. 培养皿表面消毒后,转移至生物安全柜中,去除培养皿中培养液,加入 12 ml PBS,轻轻摇晃培养皿清洗细胞,随后吸除 PBS 清洗液。




3. 将 2 ml 胰酶加入培养皿中,完全覆盖细胞,置于显微镜下观察(期间禁止摇晃培养皿),当细胞刚开始脱落时,立即转移至生物安全柜中,除去大部分胰酶,剩余约 0.5 ml 胰酶,转移至培养箱内继续消化,每 30 秒肉眼观察细胞状态,至细胞成流沙状完全脱落,转移至生物安全柜中,加入 12 ml 完全培养基,终止消化。









4. 将终止消化后的细胞悬液吹打均匀,按照适当比例分装至培养皿中,并做好标记,加入完全培养基,最后转移至二氧化碳培养箱中进行培养。


贴壁细胞如何传代?你学会了吗?如需更详细的技术指导可在下方留言或直接发送邮件至 info@bnbio.com,我们会第一时间为您解答,感谢您的支持!
1. 贴壁细胞密度达到 80%,即可进行传代,拍照,记录细胞状态。



2. 培养皿表面消毒后,转移至生物安全柜中,去除培养皿中培养液,加入 12 ml PBS,轻轻摇晃培养皿清洗细胞,随后吸除 PBS 清洗液。

4. 将终止消化后的细胞悬液吹打均匀,按照适当比例分装至培养皿中,并做好标记,加入完全培养基,最后转移至二氧化碳培养箱中进行培养。

贴壁细胞如何传代?你学会了吗?如需更详细的技术指导可在下方留言或直接发送邮件至 info@bnbio.com,我们会第一时间为您解答,感谢您的支持!




